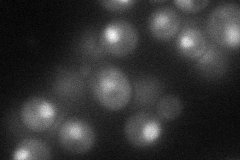
YNR023W
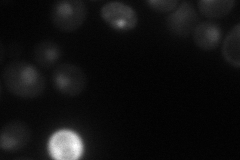
YNR023W
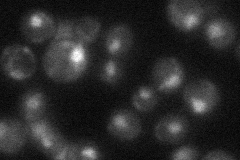
YNR023W
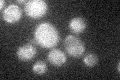
YNR023W

View description
73 kDa subunit of the SWI/SNF chromatin remodeling complex involved in transcriptional regulation; homolog of Rsc6p subunit of the RSC chromatin remodeling complex; deletion mutants are temperature-sensitive
Localization:
Intensity:
Fold change:
Significance:
-
C’ GFP library in SD

below threshold16.65 -
N' NOP1pr-GFP in SD
nucleus57.7945 -
N' TEF2pr-mCherry in SD
nucleus42.3195 -
N' NATIVEpr-GFP in SD
nucleus30.27 -
N' TEF2pr-VC and Cyto-VN in SD

below threshold28.2167 -
C’ GFP library in SD+DTT

cytosol16.390.98No -
C’ GFP library in SD+H2O2
cytosol17.591.05No -
C’ GFP library in Starvation Media

cytosol14.30.85No -
C’ GFP library on the background of Pup2-DaMP

below threshold -
C’ GFP library on the background of CCT mutant

below threshold18.04611.08294No
